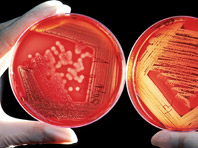
Россия всерьез займется проблемой резистентных бактерий

10 тревожных симптомов заболеваний, которые зря не воспринимаются всерьез
Часто мы игнорируем сигналы организма, которые могут помочь диагностировать серьезное заболевание на ранней стадии. Часто мы не замечаем симптомы болезни, списывая их на естественные процессы: хочется спать — не выспался, пить — давно не опустошали стаканчик. Мы игнорируем сигналы организма, которые могут помочь диагностировать заболевание на ранней стадии. Прислушайтесь к себе и прочитайте внимательно подсказки…